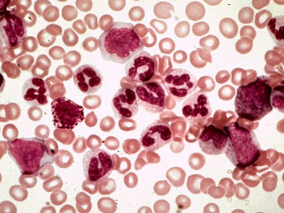
慢性粒细胞白血病慢性期的获益和风险：尼洛替尼vs伊马替尼

-
HPV及p16对放疗联合/不联合西妥昔单抗口咽癌患者疗…
环球医学资讯
 2016年06月07日
2016年06月07日 点击量:359
点击量:359 1小时条评论
1小时条评论人乳头瘤病毒(HPV)的状态是口咽癌(OPC)的一项重要风险因素,约有45%~90%的初诊口咽癌病人被诊断为HPV阳性。2016年4月,发表在《J Clin Oncol》的一项IMCL-9815研究的回顾性评估表明,p16状态是OPC患者的强烈预测因素。与单独放疗(RT)相比,将西妥昔单抗加入到...
-
分子生物学基因检测应强制性用于肉瘤的精确诊断和临…
环球医学资讯
 2016年06月07日
2016年06月07日 点击量:352
点击量:352 1小时条评论
1小时条评论肉瘤的分子遗传学的发展让我们能够识别特定类型的畸变。2016年3月,发表在《Lancet Oncol》的一项研究拟评估肉瘤分子生物学诊断的临床有效性,以期改善肉瘤误诊现象。结果表明,即使病理专家已进行相应的组织学诊断,分子生物学基因检测手段仍应强制用于肉瘤的精确诊...
-
慢性粒细胞白血病慢性期的获益和风险:尼洛替尼vs伊…
环球医学资讯
 2016年06月06日
2016年06月06日 点击量:343
点击量:343 1小时条评论
1小时条评论2016年5月,发表于《Leukemia》的一项研究考察了慢性粒细胞白血病慢性期内一线治疗药物尼洛替尼vs伊马替尼的长期获益和风险。该研究是对ENESTnd随机试验5年的更新。 在评估尼洛替尼在新确诊的患者的有效性和安全性的临床3期试验-(ENESTnd)研究中,新确诊的慢性粒...
-
使用外排体的液体活检可成为癌症诊断、治疗和监测的…
环球医学资讯
 2016年06月06日
2016年06月06日 点击量:329
点击量:329 1小时条评论
1小时条评论2016年4月,发表于《Ann Oncol》的一项研究考察了使用高分辨的基因组学和转录组学手段检查内脏癌症的前景。研究者认为,使用外排体的液体活检很有可能作为一种临床工具,用于癌症诊断、治疗和监测,而无需直接进行肿瘤采样。 背景:在精准医学中,在高分辨下,综合...
-
癌症诊断、治疗和监测的新方法:人体外排液体活检
环球医学资讯
 2016年06月06日
2016年06月06日 点击量:237
点击量:237 1小时条评论
1小时条评论2016年5月,发表于《Br J Haematol》的一项研究比较了在不匹配的无关供体造血细胞移植中移植后环磷酰胺与传统药物相比预防移植物抗宿主病的安全性和有效性。 移植后环磷酰胺(PTCy)是预防半相合造血细胞移植(HCT)后移植物抗宿主病(GVHD)的一种有效方法。我们考...
-
舒尼替尼或索拉非尼辅助治疗非转移性肾细胞癌是否有…
环球医学资讯
 2016年05月31日
2016年05月31日 点击量:138
点击量:138 1小时条评论
1小时条评论舒尼替尼和索拉非尼是口服抗血管生成制剂。2016年5月,发表在《Lancet》的一项双盲、安慰剂对照、随机、III期临床试验表明,与安慰剂相比,VEGF受体酪氨酸激酶抑制剂索拉非尼或舒尼替尼辅助治疗非转移性肾细胞癌患者没有表现出生存获益。 背景:肾细胞癌血管丰富,...
-
他汀、血脂和直肠癌风险之间的独立相关性分析
环球医学资讯
 2016年05月20日
2016年05月20日 点击量:250
点击量:250 1小时条评论
1小时条评论2016年4月,发表在《PLoS Med》的一项巢式病例对照研究考察结直肠癌风险与他汀使用、血清胆固醇和胆固醇浓度变化之间的独立相关性。结果显示,尽管他汀使用者同未使用者相比结直肠癌风险较低,但继续和停止他汀治疗患者之间没有观察到差异,这表明潜在的适应证偏倚。...
-
确诊食管癌后服用他汀可显著改善生存率
环球医学资讯
 2016年05月20日
2016年05月20日 点击量:119
点击量:119 1小时条评论
1小时条评论他汀类药物是一种用于预防心血管疾病的药物,然而现在越来越多的研究聚焦于该类药物的抗癌特性。2016年5月,发表在《Ann Rheum Dis》的一项研究显示,在大规模基于人群的队列中,在确诊食管腺癌后使用他汀类药物,并非食管鳞状细胞癌,与食管癌特异性和全因死亡率降...
-
接受化疗的非骨髓恶性肿瘤合并贫血患者:isomaltosi…
环球医学资讯
 2016年05月16日
2016年05月16日 点击量:425
点击量:425 1小时条评论
1小时条评论2016年4月,发表在《Pharmacotherapy》的一项III期、前瞻性、开放标签、比较性、随机、非劣效性、多中心研究表明,接受化疗的非骨髓恶性肿瘤合并贫血患者中,使用铁剂isomaltoside和口服硫酸铁随着时间的推移血红蛋白浓度持续增加相似。铁剂isomaltoside比口服铁剂耐...
-
前列腺癌一线长期激素治疗添加多西他赛唑来膦酸是否…
环球医学资讯
 2016年05月11日
2016年05月11日 点击量:372
点击量:372 1小时条评论
1小时条评论长期激素治疗已被用于治疗前列腺癌50年以上。本世纪以来,在复发转移去势难治性前列腺癌患者中,新的药物显示出有价值的活性。2016年3月,发表在《Lancet》的一项研究显示,对于适合开始长期激素治疗的男性患者,多西他赛应成为标准治疗的一部分。 背景:自20世纪40...

会员登录
会员登录

